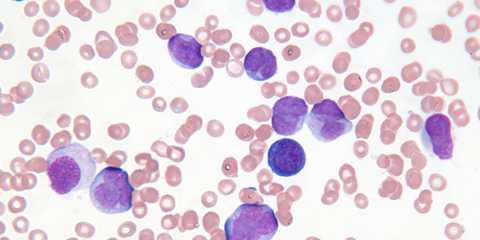
Причины развития неходжкинских лимфом

Хронический лимфолейкоз - причины, механизмы развития
Добавил пользователь Алексей Ф. Обновлено: 11.12.2025
Хронический лимфолейкоз — злокачественное лимфопролиферативное заболевание, при котором опухолевыми клетками являются патологические В-лимфоциты, способные накапливаться в костном мозге, периферической крови и лимфатических узлах. В норме В-лимфоциты в течение своей жизни превращаются в иммуноглобулинсекретирующую клетку, которая обеспечивает приобретённый иммунитет. Опухолевые В-лимфоциты такой функции лишены, и, таким образом, иммунитет больного страдает, и повышается риск присоединения инфекционных заболеваний. Помимо этого, по мере прогрессирования заболевания нарушается выработка эритроцитов, нейтрофилов и тромбоцитов, возможно развитие аутоиммунных процессов. Наконец, хронический лимфолейкоз может трансформироваться в В-клеточный пролимфоцитарный лейкоз, в высокодифференцированную неходжкинскую лимфому, в частности — в диффузную В-крупноклеточную лимфому.
Причины развития лимфолейкоза
Хронический лейкоз является самым распространённым видом лейкоза, составляя до 30% в общей структуре заболеваемости. Частота встречаемости составляет 4 случая на 100 тысяч населения; у лиц старше 80 лет частота составляет более 30 случаев на 100 тысяч населения.
Факторами риска развития хронического лимфолейкоза являются:
- Пожилой возраст. До 70% всех выявленных случаев приходится на людей старше 60 лет,
- Мужской пол. Мужчины заболевают в два раза чаще женщин,
- Воздействие ионизирующего излучения,
- Контакт с бензолом и бензином.
Симптомы
Для хронического лимфолейкоза характерно длительное бессимптомное течение; основной причиной обращения к врачу являются изменения в общем анализе крови, сданном в рамках профилактического осмотра или по поводу иного заболевания. Активных жалоб на момент первичного осмотра пациент может и не предъявлять, но при этом зачастую даже в этой ситуации уже выявляется увеличение лимфатических узлов и изменение их консистенции до тестоватой. Сами лимфоузлы не уплотнены, сохраняют подвижность относительно окружающих тканей. В случае присоединения инфекции лимфатические узлы значительно увеличиваются; по мере прогрессирования хронического лимфолейкоза лимфоузлы — в первую очередь брюшной полости — способны
образовывать конгломераты.
Первые возникающие жалобы обычно не носят специфического характера: повышенная утомляемость, слабость, выраженная потливость. По мере развития заболевания могут возникнуть аутоиммунные проявления, в первую очень гемолитические анемии (в 10-25% случаев) и тромбоцитопении (в 2-3% случаев). Гемолитическая анемия развивается в связи с разрушением самим организмом эритроцитов; чаще всего развивается, как и сам хронический лимфолейкоз, постепенно, но может проявиться и острым кризом — с повышением температуры, появлением желтухи, потемнения мочи. Тромбоцитопения может быть гораздо более опасным состоянием в связи с развитием кровотечений, в том числе и жизнеугрожающих (например, кровоизлияния в головной мозг).
Кроме того, так как В-лимфоциты относятся к клеткам, обеспечивающим иммунитет, типичным является присоединение инфекционных осложнений, в том числе оппортунистических, то есть вызванных микроорганизмами, постоянно находящимися в человеческом организме и не проявляющими себя при адекватном иммунном ответе. Чаще всего оппортунистическими инфекциями поражаются лёгкие.
Диагностика хронического лимфолейкоза
Диагноз хронического лимфолейкоза может быть заподозрен при оценке результатов обычного клинического анализа крови — обращает на себя внимание увеличение абсолютного количества лимфоцитов и лейкоцитов. Основным диагностическим критерием является абсолютное количество лимфоцитов, превышающее 5×10 9 \л и прогрессивно увеличивающееся по мере развития лимфолейкоза, достигая цифр 100-500×10 9 \л. Важно обращать внимание не только на абсолютное число, — если в начале заболевания лимфоциты составляют до 60-70% от всего количества лейкоцитов, то при его дальнейшем развитии они могут составлять 95-99%. Другие показатели крови, такие, как гемоглобин и тромбоциты, могут быть в норме, но при прогрессировании заболевания может быть выявлено их снижение. Абсолютным критерием для установки диагноза «хронический лимфолейкоз» является выявление более 5000 клональных В-лимфоцитов в 1 мкл периферической крови.
В биохимическом анализе крови может быть выявлено снижение общего белка и количества иммуноглобулинов, но это характерно для более поздних стадий заболевания. Обязательным этапом в диагностическом поиске является трепанбиопсия костного мозга. При гистологическом исследовании полученного пунктата на ранних этапах заболевания так же, как и в общем анализе крови, обнаруживается небольшое содержание лимфоцитов (40-50%), но при высоком лейкоцитозе лимфоциты могут составлять 95-98% костномозговых элементов.
Так как изменения в костном мозге являются неспецифическими, окончательный диагноз хронического лимфолейкоза устанавливается на основании данных иммуногистохимического исследования. Характерный иммунофенотип хронического лимфолейкоза включает экспрессию антигенов CD19, CD5, CD20, CD23, также отмечается слабая экспрессия на поверхности клеток иммуноглобулинов IgM (нередко одновременно с IgD) и антигенов CD20 и CD22. Главным цитогенетическим маркером, непосредственно влияющим на выбор терапии, является делеция 17p. Желательно выполнять анализ, направленный на выявлении этой делеции, до начала лечения, так как её выявление приводит к изменению тактики ведения пациента. Помимо биопсии костного мозга, в случае значительного увеличения отдельных лимфатических узлов показана пункция и их с целью исключения лимфомы.
Из инструментальных методов диагностики проводятся рентгенография органов грудной клетки и УЗИ наиболее часто поражаемых групп лимфоузлов и органов брюшной полости - в первую очередь печени и селезёнки, так как именно эти органы чаще всего поражаются при хроническом лимфолейкозе.

Стадии заболевания
В настоящее время стадирование осуществляется согласно классификации, предложенной Binet:
- A — содержание гемоглобина более 100 г\л, тромбоцитов — более 100×10 9 \л, поражено менее трёх лимфатических областей (к ним относятся: шейные лимфоузлы, подмышечные лимфоузлы, паховые лимфоузлы, печень, селезёнка),
- B — содержание гемоглобина более 100 г\л, тромбоцитов — более 100×10 9 \л, поражено более трёх лимфатических областей,
- C — содержание гемоглобина менее 100 г\ или тромбоцитов — менее 100×10 9 \л.
Помимо классификации по Binet, используется классификация по Rai, используемая преимущественно в США. Согласно ей, выделяют четыре стадии заболевания:
- 0 — клинические проявления включают в себя только повышение лимфоцитов более 15×10 9 в периферической крови и более 40% в костном мозге,
- I — повышено количество лимфоцитов, диагностируется увеличение лимфоузлов,
- II — повышено количество лимфоцитов, диагностируется увеличение печени и\или селезёнки вне зависимости от увеличения лимфоузлов,
- III — наблюдается повышение количества лимфоцитов и снижение уровня гемоглобина менее 110 г\л вне зависимости от увеличения селезёнки, печени и лимфоузлов,
- IV — наблюдается повышение количества лимфоцитов и снижение числа тромбоцитов менее 100×10 9 вне зависимости от уровня гемоглобина, увеличения органов и лимфоузлов.
0 стадия характеризуется благоприятным прогнозом, I и II — промежуточным, III и IV — неблагоприятным.
Лечение
В настоящее время хронический лимфолейкоз хорошо поддаётся лечению благодаря широкому спектру химиотерапевтических препаратов. Важно отметить, что современные руководства не рекомендуют начинать агрессивное лечение сразу же после установки диагноза — в случаях, когда клинические проявления минимальны, возможно активное динамическое наблюдение до момента возникновения показаний к проведению специфического лечения, к коим относятся:
- Возникновение или нарастание интоксикации, которая проявляется потерей массы тела более чем на 10% за полгода, ухудшением общего состояния; появление лихорадки, субфебрильной температуры, ночных потов.
- Нарастание явлений анемии и/или тромбоцитопении;
- Аутоиммунная анемия и/или тромбоцитопения — в случае, если состояние не корректируется преднизолоном;
- Значительные размеры селезёнки — нижний край на расстоянии >6 см и более ниже рёберной дуги;
- Размер поражённых лимфатических узлов более 10 см или его прогрессивное увеличение;
- Увеличение количества лимфоцитов более, чем на 50% за 2 месяца, или вдвое за 6 месяцев.
Основным методом лечения хронического лимфолейкоза на данный момент является химиотерапия. Один из первых химиотерапевтических агентов, показавших свою эффективность в лечении хронического лимфолейкоза, хлорамбуцил, используется и в настоящее время, хоть и ограниченно. С течением времени вместо хлорамбуцила стали использовать циклофосфамид, в комбинации с другими препаратами, и соответствующие схемы (например, CHOP, COP, CAP) на данный момент применяются у пациентов молодого возраста с хорошим соматическим статусом.
Впервые введённый в клиническую практику в 80-х годах прошлого века флударабин показал эффективность в отношении достижения стойкой ремиссии, превышающую эффективность хлорамбуцила, особенно в сочетании с циклофосфамидом. Важно отметить, что эта схема эффективна даже в случае развития рецидива заболевания. Последним словом в лечении хронического лейкоза в настоящее время является применение иммунотерапевтических средств — препаратов из группы моноклональных тел. В рутинную клиническую практику прочно вошел ритуксимаб. Данный препарат взаимодействует с антигеном CD20, который ограниченно экспрессируется при хроническом лимфолейкозе, поэтому для эффективного лечения требуется сочетание ритуксимаба с какой-либо из принятых схем химиотерапии, чаще всего с флударабином или COP. Ритуксимаб в монорежиме может применяться как поддерживающая терапия при частичном ответе на лечение.
Перспективным выглядит применение препарата алемтузумаб, который взаимодействует с антигеном CD52. Его также используют как в монорежиме, так и в комбинации с флударабином.
Отдельно хотелось бы упомянуть хронический лимфолейкоз с делецией 17p. Этот подтип лимфолейкоза часто бывает резистентен к стандартным схемам химиотерапии.
Определённые успехи в лечении этого подвида лимфолейкоза достигнуты благодаря применению упомянутого выше алемтузумаба. Кроме того, перспективным средством в этой ситуации является ибрутиниб. В настоящее время этот препарат применяется в монорежиме, сочетание его с различными схемами химиотерапии исследуется; определённое преимущество показала схема, включающая ибрутиниб, ещё одно моноклональное тело — ритуксимаб, и бендамустин.

Лучевая терапия, которая столетие назад была практически единственной возможностью лечения таких больных, и по сей день не утратила актуальности: рекомендуется её проведение в рамках комплексного подхода на область поражённых лимфоузлов, если наблюдается их продолженный рост на фоне стабилизации остальных проявлений заболевания. В этом случае необходимая суммарная доза составляет 20-30 Гр. Также лучевой метод может быть применён при рецидивах заболевания.
В лечении хронического лимфолейкоза нашёл своё место и хирургический метод, заключающийся в удалении поражённой селезёнки. Показаниями к данному вмешательству являются:
- Увеличение селезёнки в сочетании с тяжелой анемией и/или тромбоцитопенией, особенно если наблюдается химиорезистентность,
- Массивное увеличение селезёнки при условии отсутствия ответа на химиотерапию,
- Тяжёлая аутоиммунная анемия и/или тромбоцитопения при резистентности к медикаментозному лечению.
При развитии резистентности к применяемым ранее химиотерапевтическим агентам или же при быстром прогрессировании после проведённого лечения может быть проведена трансплантация костного мозга. Трансплантация костного мозга показана в первой ремиссии пациентам из группы высокого риска, молодым пациентам в отсутствие эффекта от проводимого лечения, пациентам с делецией 17p/мутацией TP53 при наличии прогрессии заболевания. Важно отметить, что после проведённой трансплантации рекомендуется применение ритуксимаба и леналидомида в качестве поддерживающей терапии с целью предотвращения рецидива.
Наконец, пациентам требуется проведение и поддерживающей терапии, которая включает:
- Переливание эритроцитарной массы при анемии;
- Переливание тромбоцитарной массы при кровотечении, вызванном тромбоцитопенией;
- Противомикробные средства при присоединении бактериальной, грибковой или вирусной инфекции, а также для её профилактики;
- Применение преднизолона в дозе 1-2 мг/кг при развитии аутоиммунных процессов.
В случае развития рецидива заболевания тактика лечения зависит от ряда факторов, таких как: проведённая ранее терапия, срок наступления рецидива, клиническая картина. В случае раннего (то есть возникшего в периоде 24 месяцев и ранее) рецидива основным препаратом является ибрутиниб. Он применяется как самостоятельно, так и в составе упомянутой выше схемы лечения (ибрутиниб+ритуксимаб+бендамустин).
Альтернативным препаратом выбора может быть алемтузумаб. Демонстрируя сопоставимую с ибрутинибом эффективность, он, однако, демонстрирует значительно большую токсичность.
Наконец, у ряда пациентов по поводу раннего рецидива хронического лимфолейкоза может быть выполнена трансплантация костного мозга.
В случае позднего (возникшего в срок более 24 месяцев с момента завершения лечения) рецидива основным критерием выбора является проведённая ранняя терапия.
- Если проводимая ранее терапия на основе флударабина не сопровождалась значительной токсичностью, то можно вернуться к этой схеме, а также дополнить её ритуксимабом.
- В случае выявления цитопении возможно применение ритуксимаба в сочетании с высокими дозами глюкокортикостероидов.
- При проведённом ранее лечении хлорамбуцилом показано применение схем с флударабином или сочетанием бендамустина и ритуксимаба.
- Монотерапия ибрутинибом или его сочетание с одной из схем полихимиотерапии также может быть эффективна при рецидиве хронического лимфолейкоза.
Оценка эффективности лечения
Диагностические исследования, направленные на оценку эффекта от проведённого лечения, проводятся не ранее, чем через 2 месяца после окончания последнего курса химиотерапии. Результат может быть оценён следующим образом:
- Полная ремиссия: уменьшение до нормальных размеров печени, селезёнки, лимфоузлов (допустимо их увеличение в размере не более чем 1,5 см), снижение числа лимфоцитов менее 4×10 9 \л в периферической крови и менее 30% в костном мозге, повышение числа тромбоцитов более 100×10 9 \л, гемоглобина — более 110 г\л, нейтрофилов — более 1,54×10 9 \л.
- Частичная ремиссия: уменьшение размеров лимфоузлов, печени и селезёнки на 50% и более, снижение количества лимфоцитов в периферической крови на 50%, повышение числа тромбоцитов более 100×10 9 \л, гемоглобина — более 110 г\л, нейтрофилов — более 1,54×10 9 \л или же повышение любого из этих параметров более чем на 50% от исходного уровня.
- Признаками прогрессирования заболевания являются, напротив, увеличение размеров лимфоузлов, печени и селезёнки на 50% и более, а также уменьшение количества тромбоцитов на 50% и более от исходного уровня и уменьшение количества тромбоцитов на 20 г\л и более.
Для установления полной ремиссии необходимо соблюдение всех перечисленных критериев, частичной — по крайней мере 2 критерия, касающихся состояния внутренних органов, и минимум одного критерия, касающегося клеточного состава крови.
Следует учитывать, что терапия ибрутинибом может привести к полному ответу со стороны лимфатических узлов и селезёнки, но с сохранением лейкоцитоза в периферической крови. Это состояние обозначается, как частичный ответ с лимфоцитозом.
Прогноз
Значительные успехи в терапии хронического лимфолейкоза позволили сделать это заболевание потенциально излечимым или же достаточно долго поддерживать жизнь человека без прогрессирования основного заболевания с сохранением её качества.
Напротив, без лечения заболевание медленно, но неуклонно прогрессирует, что способно стать причиной гибели пациента спустя несколько лет после дебюта заболевания, поэтому своевременное обращение к врачу и начало адекватной терапии очень важны.
Острый лимфобластный лейкоз
Острый лимфобластный лейкоз - злокачественное поражение системы кроветворения, сопровождающееся неконтролируемым увеличением количества лимфобластов. Проявляется анемией, симптомами интоксикации, увеличением лимфоузлов, печени и селезенки, повышенной кровоточивостью и дыхательными расстройствами. Из-за снижения иммунитета при остром лимфобластном лейкозе часто развиваются инфекционные заболевания. Возможно поражение ЦНС. Диагноз выставляется на основании клинических симптомов и данных лабораторных исследований. Лечение - химиотерапия, радиотерапия, пересадка костного мозга.
МКБ-10

Общие сведения
В соответствии с классификацией ВОЗ различают четыре типа ОЛЛ: пре-пре-В-клеточный, пре-В-клеточный, В-клеточный и Т-клеточный. В-клеточные острые лимфобластные лейкозы составляют 80-85% от общего количества случаев заболевания. Первый пик заболеваемости приходится на возраст 3 года. В последующем вероятность развития ОЛЛ повышается после 60 лет. Т-клеточный лейкоз составляет 15-20% от общего количества случаев болезни. Пик заболеваемости приходится на возраст 15 лет.

Причины острого лимфобластного лейкоза
Непосредственной причиной острого лимфобластного лейкоза является образование злокачественного клона - группы клеток, обладающих способностью к неконтролируемому размножению. Клон образуется в результате хромосомных аберраций: транслокации (обмена участками между двумя хромосомами), делеции (утраты участка хромосомы), инверсии (переворота участка хромосомы) или амплификации (образования дополнительных копий участка хромосомы). Предполагается, что генетические нарушения, вызывающие развитие острого лимфобластного лейкоза, возникают еще во внутриутробном периоде, однако для завершения процесса формирования злокачественного клона нередко требуются дополнительные внешние обстоятельства.
В числе факторов риска возникновения острого лимфобластного лейкоза обычно в первую очередь указывают лучевые воздействия: проживание в зоне с повышенным уровнем ионизирующей радиации, радиотерапию при лечении других онкологических заболеваний, многочисленные рентгенологические исследования, в том числе во внутриутробном периоде. Уровень связи, а также доказанность наличия зависимости между различными лучевыми воздействиями и развитием острого лимфобластного лейкоза сильно различаются.
Так, взаимосвязь между лейкозами и лучевой терапией в наши дни считается доказанной. Риск возникновения острого лимфобластного лейкоза после радиотерапии составляет 10%. У 85% пациентов болезнь диагностируется в течение 10 лет после окончания курса лучевой терапии. Связь между рентгенологическими исследованиями и развитием острого лимфобластного лейкоза в настоящее время остается на уровне предположений. Достоверных статистических данных, подтверждающих эту теорию, пока не существует.
Многие исследователи указывают на возможную связь между ОЛЛ и инфекционными заболеваниями. Вирус возбудителя острого лимфобластного лейкоза пока не выявлен. Существуют две основные гипотезы. Первая - ОЛЛ вызывается одним пока не установленным вирусом, однако болезнь возникает только при наличии предрасположенности. Вторая - причиной развития острого лимфобластного лейкоза могут стать разные вирусы, риск развития лейкоза у детей повышается при недостатке контактов с патогенными микроорганизмами в раннем возрасте (при «нетренированности» иммунной системы). Пока обе гипотезы не доказаны. Достоверные сведения о наличии связи между лейкозами и вирусными заболеваниями получены только для Т-клеточных лейкозов у взрослых больных, проживающих в странах Азии.
Вероятность развития острого лимфобластного лейкоза повышается при контакте матери с некоторыми токсическими веществами в период гестации, при некоторых генетических аномалиях (анемии Фанкони, синдроме Дауна, синдроме Швахмана, синдроме Клайнфельтера, синдроме Вискотта-Олдрича, нейрофиброматозе, целиакии, наследственно обусловленных иммунных нарушениях), наличии онкологических заболеваний в семейном анамнезе и приеме цитостатиков. Некоторые специалисты отмечают возможное негативное влияние курения.
Симптомы острого лимфобластного лейкоза
Болезнь развивается стремительно. К моменту постановки диагноза суммарная масса лимфобластов в организме может составлять 3-4% от общей массы тела, что обусловлено бурной пролиферацией клеток злокачественного клона на протяжении 1-3 предыдущих месяцев. В течение недели количество клеток увеличивается примерно вдвое. Различают несколько синдромов, характерных для острого лимфобластного лейкоза: интоксикационный, гиперпластический, анемический, геморрагический, инфекционный.
Интоксикационный синдром включает в себя слабость, утомляемость, лихорадку и потерю веса. Повышение температуры может провоцироваться как основным заболеванием, так и инфекционными осложнениями, которые особенно часто развиваются при наличии нейтропении. Гиперпластический синдром при остром лимфобластном лейкозе проявляется увеличением лимфоузлов, печени и селезенки (в результате лейкемической инфильтрации паренхимы органов). При увеличении паренхиматозных органов могут появляться боли в животе. Увеличение объема костного мозга, инфильтрация надкостницы и тканей суставных капсул могут становиться причиной ломящих костно-суставных болей.
О наличии анемического синдрома свидетельствуют слабость, головокружения, бледность кожи и учащение сердечных сокращений. Причиной развития геморрагического синдрома при остром лимфобластном лейкозе становятся тромбоцитопения и тромбозы мелких сосудов. На коже и слизистых выявляются петехии и экхимозы. При ушибах легко возникают обширные подкожные кровоизлияния. Наблюдаются повышенная кровоточивость из ран и царапин, кровоизлияния в сетчатку, десневые и носовые кровотечения. У некоторых больных острым лимфобластным лейкозом возникают желудочно-кишечные кровотечения, сопровождающиеся кровавой рвотой и дегтеобразным стулом.
Иммунные нарушения при остром лимфобластном лейкозе проявляются частым инфицированием ран, царапин и следов от уколов. Могут развиваться различные бактериальные, вирусные и грибковые инфекции. При увеличении лимфатических узлов средостения отмечаются нарушения дыхания, обусловленные уменьшением объема легких. Дыхательная недостаточность чаще обнаруживается при Т-клеточном остром лимфобластном лейкозе. Нейролейкозы, спровоцированные инфильтрацией оболочек спинного и головного мозга, чаще отмечаются во время рецидивов.
При вовлечении ЦНС выявляются положительные менингеальные симптомы и признаки повышения внутричерепного давления (отек дисков зрительных нервов, головная боль, тошнота и рвота). Иногда поражение ЦНС при остром лимфобластном лейкозе протекает бессимптомно и диагностируется только после исследования цереброспинальной жидкости. У 5-30% мальчиков появляются инфильтраты в яичках. У пациентов обоих полов на коже и слизистых оболочках могут возникать багрово-синюшные инфильтраты (лейкемиды). В редких случаях наблюдаются выпотной перикардит и нарушения функции почек. Описаны случаи поражений кишечника.
С учетом особенностей клинической симптоматики можно выделить четыре периода развития острого лимфобластного лейкоза: начальный, разгара, ремиссии, терминальный. Продолжительность начального периода составляет 1-3 месяца. Преобладает неспецифическая симптоматика: вялость, утомляемость, ухудшение аппетита, субфебрилитет и нарастающая бледность кожи. Возможны головные боли, боли в животе, костях и суставах. В период разгара острого лимфобластного лейкоза выявляются все перечисленные выше характерные синдромы. В период ремиссии проявления болезни исчезают. Терминальный период характеризуется прогрессирующим ухудшением состояния больного и завершается летальным исходом.
Диагностика острого лимфобластного лейкоза
Диагноз выставляют с учетом клинических признаков, результатов анализа периферической крови и данных миелограммы. В периферической крови пациентов с острым лимфобластным лейкозом выявляются анемия, тромбоцитопения, повышение СОЭ и изменение количества лейкоцитов (обычно - лейкоцитоз). Лимфобласты составляют 15-20 и более процентов от общего количества лейкоцитов. Количество нейтрофилов снижено. В миелограмме преобладают бластные клетки, определяется выраженное угнетение эритроидного, нейтрофильного и тромбоцитарного ростка.
В программу обследования при остром лимфобластном лейкозе входят люмбальная пункция (для исключения нейролейкоза), УЗИ органов брюшной полости (для оценки состояния паренхиматозных органов и лимфатических узлов), рентгенография грудной клетки (для обнаружения увеличенных лимфоузлов средостения) и биохимический анализ крови (для выявления нарушений функции печени и почек). Дифференциальный диагноз острого лимфобластного лейкоза проводят с другими лейкозами, отравлениями, состояниями при тяжелых инфекционных заболеваниях, инфекционным лимфоцитозом и инфекционным мононуклеозом.
Лечение и прогноз при остром лимфобластном лейкозе
Основой терапии являются химиопрепараты. Выделяют два этапа лечения ОЛЛ: этап интенсивной терапии и этап поддерживающей терапии. Этап интенсивной терапии острого лимфобластного лейкоза включает в себя две фазы и длится около полугода. В первой фазе осуществляют внутривенную полихимиотерапию для достижения ремиссии. О состоянии ремиссии свидетельствуют нормализация кроветворения, наличие не более 5% бластов в костном мозге и отсутствие бластов в периферической крови. Во второй фазе проводят мероприятия для продления ремиссии, замедления или прекращения пролиферации клеток злокачественного клона. Введение препаратов также осуществляют внутривенно.
Продолжительность этапа поддерживающей терапии при остром лимфобластном лейкозе составляет около 2 лет. В этот период больного выписывают на амбулаторное лечение, назначают препараты для перорального приема, осуществляют регулярные обследования для контроля над состоянием костного мозга и периферической крови. План лечения острого лимфобластного лейкоза составляют индивидуально с учетом уровня риска у конкретного больного. Наряду с химиотерапией используют иммунохимиотерапию, радиотерапию и другие методики. При низкой эффективности лечения и высоком риске развития рецидивов осуществляют трансплантацию костного мозга. Средняя пятилетняя выживаемость при В-клеточном остром лимфобластном лейкозе в детском возрасте составляет 80-85%, во взрослом - 35-40%. При Т-лимфобластном лейкозе прогноз менее благоприятен.
Хронический лимфоцитарный лейкоз: причины возникновения, симптомы, диагностика, стадии, лечение
Хронический лимфоцитарный лейкоз (ХЛЛ) — это злокачественное заболевание кроветворной ткани, характеризующееся опухолевой трансформацией одного клона лимфоцитов с последующей экспансией им костного мозга, крови, лимфатических узлов и внутренних органов. Злокачественные клетки замещают нормальные, что приводит к дисфункции пораженных органов, расстройствам кровообращения и иммунной защиты.
Одним из первых лабораторных признаков лимфолейкоза является кратное увеличение количества лейкоцитов в периферической крови.
Содержание:
Причины развития хронического лимфолейкоза
К возможным этиологическим факторам развития хронического лимфолейкоза относят:
- хромосомные мутации
- наследственная предрасположенность
- вирусные инфекции
По мнению ряда ученых, длительная стимуляция иммунной системы человека (например, при частых инфекциях) может приводить к генетическим поломкам и опухолевому перерождению лимфоцитов, образованию клона лейкемических клеток и возникновению ХЛЛ.
Прямой причинной связи между воздействием канцерогенов, ионизирующего излучения и возникновением ХЛЛ не установлено.
Механизм развития хронического лимфолейкоза заключается в преобразовании лимфоцитов в опухолевые клетки и их размножении, что приводит к угнетению нормального кроветворения, развитию анемии и тромбоцитопении.
Симптомы хронического лимфолейкоза
В начальной стадии ХЛЛ пациенты не предъявляют жалоб, их общее состояние удовлетворительное. У некоторых могут проявляться такие неспецифические симптомы как: сильная потливость, быстрая утомляемость, слабость, частые простуды. На данном этапе ХЛЛ выявляется, как правило, случайно на профилактическом осмотре или при обращении к доктору по поводу другого заболевания. Заболевание проявляется абсолютным лимфоцитозом в общем анализе крови и увеличением периферических групп лимфатических узлов (шейных, подмышечные, паховые). Увеличенные лимфоузлы при ХЛЛ пальпаторно мягко — эластичные, безболезненные, не спаяны с окружающими тканями, кожа над ними не изменена.
При медленном течении начальная стадия может длиться несколько лет, при прогрессирующем течении наблюдается быстрое ухудшение общего состояния, значительное увеличение лимфоузлов и селезенки.
Для развернутой стадии ХЛЛ характерна выраженность симптомов. К основным клиническим проявлениям относят:
- синдром интоксикации: выраженная слабость, быстрая утомляемость, снижение работоспособности, резкое снижение массы тела, значительная потливость в ночное время, необъяснимое повышение температуры тела;
- прогрессирующая лимфоаденопатия: увеличиваются практически все группы лимфатических узлов. На ощупь они мягко-эластичные, безболезненные, не спаяны с окружающими тканями, могут сливаться в конгломераты;
- инфильтрация опухолевыми клетками всех органов и систем со снижением их функции.
При этом наблюдаются:
- увеличение селезенки;
- увеличение печени, с чем связаны синдромы портальной гипертензии (расширение вен пищевода, скопление свободной жидкости в брюшной полости, печеночная недостаточность) и холестатической желтухи (боль в правом подреберье, тошнота, окрашивание кожи и склер в желтый цвет, кожный зуд, обесцвечивание кала, потемнение мочи);
- язвы ЖКТ, синдром мальабсорбции (нарушение всасывания в кишечнике, сопровождающееся болями в животе, диареей), диспепсические нарушения (тошнота, вздутие, чувство тяжести), как следствие инфильтрации ЖКТ;
- частые пневмонии и другие инфекции дыхательных путей, дыхательная недостаточность, вследствие накопления опухолевых клеток в легких.
В общем анализе крови — лейкоцитоз (50-200*109/л), лимфоцитоз (до 100*109/л или 80-90 % в лейкоцитарной формуле), анемия и тромбоцитопения, увеличение СОЭ, клеток Боткина — Гумпрехта (разрушенные лимфоциты).
Терминальная стадия ХЛЛ характеризуется:
- резким значительным ухудшением общего состояния;
- длительной высокой температурой тела;
- истощением;
- тяжелыми генерализованными инфекциями (стафилококковой, стрептококковой, герпетической, туберкулезом и др.);
- тяжелой почечной недостаточностью (характеризуется олигоанурией, повышением в крови мочевины и креатинина);
- выраженной анемией;
- выраженная тромбоцитопения;
- геморрагический синдром;
- в связи с инфильтрацией мозговых оболочек опухолевыми клетками возможно развитие нейролейкемии, проявляющейся сильной головной болью, рвотой, парезами и параличами, развитием менингеальных симптомов;
- инфильтрация спинномозговых корешков сопровождается интенсивными стреляющими «корешковыми» болями;
- возможно развитие тяжелой кардиомиопатии, проявляющейся прогрессирующей сердечной недостаточностью и нарушениями ритма сердца.
Диагностика хронического лимфоцитарного лейкоза включает в себя сбор анамнеза и уточнение жалоб у пациента, общий осмотр, который заключается в прощупывании периферических лимфатических узлов, печени и селезенки.
Лабораторные методы исследования ХЛЛ
- Общий анализ крови с лейкоцитарной формулой (оценка количества эритроцитов, лейкоцитов, тромбоцитов, СОЭ, определение наличия в мазке крови клеток Боткина — Гумпрехта). Основной диагностический критерий абсолютный лимфоцитоз (более 5*109/л).
- Общий анализ мочи.
- Биохимический анализ крови (оценка уровня общего белка и белковых фракций, билирубина, креатинина, мочевины, ЛДГ, железа, щелочной фосфатазы, глюкозы).
- Исследование коагулограммы.
- Иммунологический анализ крови — оценка количества и функций иммунных клеток крови, присутствие в ней антител (определение количества В — и Т-лимфоцитов, субпопуляций Т-лимфоцитов, иммуноглобулинов, ревматоидного фактора, циркулирующих иммунных комплексов).
- Иммунофенотипирование лимфоцитов — исследование лимфоцитов с помощью специальных маркеров, которое позволяет определить их принадлежность к определенному виду.
- Цитологическое исследование костного мозга с миелограммой.
- Цитогенетическое исследование.
- ПЦР-диагностика вирусных инфекций.
Инструментальные методы исследования ХЛЛ
- Рентгенография органов грудной клетки.
- Ультразвуковое исследование периферических лимфатических узлов и органов брюшной полости, почек.
- Компьютерная томография органов грудной клетки, брюшной полости, малого таза.
- ЭКГ и эхокардиография.
- Эндоскопические исследования (фиброгастродуоденоскопия и колоноскопия).
Также проводятся трепанобиопсия костного мозга и биопсия лимфатических узлов с последующим гистологическим и иммуногистохимическим исследованиями.
Стадии хронического лимфолейкоза
Существует две системы стадирования ХЛЛ, в основы которых положен единый принцип: учет массы опухоли (лимфоцитоз), размеры лимфатических узлов, степень увеличения печени и селезенки, наличие или отсутствие анемии и тромбоцитопении. Совокупность данных фактор влияет на продолжительность жизни и предопределяет прогноз.
Хронический лимфолейкоз
Хронический лимфолейкоз - это онкологическое заболевание, сопровождающееся накоплением атипичных зрелых В-лимфоцитов в периферической крови, печени, селезенке, лимфоузлах и костном мозге. На начальных стадиях проявляется лимфоцитозом и генерализованной лимфоаденопатией. При прогрессировании хронического лимфолейкоза наблюдаются гепатомегалия и спленомегалия, а также анемия и тромбоцитопения, проявляющиеся слабостью, утомляемостью, петехиальными кровоизлияниями и повышенной кровоточивостью. Отмечаются частые инфекции, обусловленные снижением иммунитета. Диагноз устанавливается на основании лабораторных исследований. Лечение - химиотерапия, пересадка костного мозга.

Хронический лимфолейкоз - заболевание из группы неходжкинских лимфом. Сопровождается увеличением количества морфологически зрелых, но неполноценных В-лимфоцитов. Хронический лимфолейкоз является самой распространенной формой гемобластозов, составляет треть всех лейкозов, диагностируемых в США и странах Европы. Мужчины страдают чаще женщин. Пик заболеваемости приходится на возраст 50-70 лет, в этом периоде выявляется около 70% от общего количества хронических лимфолейкозов.
Пациенты молодого возраста страдают редко, до 40 лет первые симптом болезни возникают всего у 10% больных. В последние годы специалисты отмечают некоторое «омоложение» патологии. Клиническое течение хронического лимфолейкоза очень вариативно, возможно как продолжительное отсутствие прогрессирования, так и крайне агрессивный вариант с летальным исходом в течение 2-3 лет после постановки диагноза. Существует ряд факторов, позволяющих прогнозировать течение заболевания. Лечение осуществляют специалисты в области онкологии и гематологии.
Причины
Причины возникновения окончательно не выяснены. Хронический лимфолейкоз считается единственным лейкозом с неподтвержденной связью между развитием заболевания и неблагоприятными факторами внешней среды (ионизирующим излучением, контактом с канцерогенными веществами). Специалисты считают, что основным фактором, способствующим развитию хронического лимфолейкоза, является наследственная предрасположенность. Типичные хромосомные мутации, вызывающие повреждения онкогенов на начальной стадии болезни, пока не выявлены, однако исследования подтверждают мутагенную природу заболевания.
Патогенез
Клиническая картина хронического лимфолейкоза обусловлена лимфоцитозом. Причиной лимфоцитоза становится появление большого количества морфологически зрелых, но иммунологически дефектных В-лимфоцитов, неспособных к обеспечению гуморального иммунитета. Ранее считали, что аномальные В-лимфоциты при хроническом лимфолейкозе являются долго живущими клетками и редко подвергаются делению. В последующем эта теория была опровергнута.
Исследования показали, что В-лимфоциты быстро размножаются. Ежедневно в организме больного образуется 0,1-1% от общего количества атипичных клеток. У разных больных поражаются различные клоны клеток, поэтому хронический лимфолейкоз можно рассматривать как группу близкородственных заболеваний с общим этиопатогенезом и сходной клинической симптоматикой.
При изучении клеток выявляется большое разнообразие. В материале могут преобладать широкоплазменные либо узкоплазменные клетки с молодыми либо сморщенными ядрами, почти бесцветной либо ярко окрашенной зернистой цитоплазмой. Пролиферация аномальных клеток происходит в псевдофолликулах - скоплениях лейкозных клеток, располагающихся в лимфоузлах и костном мозге.
Причинами цитопении при хроническом лимфолейкозе являются аутоиммунное разрушение форменных элементов крови и подавление пролиферации стволовых клеток, обусловленное повышением уровня Т-лимфоцитов в селезенке и периферической крови. Кроме того, при наличии киллерных свойств разрушение кровяных клеток могут вызывать атипичные В-лимфоциты.
Классификация
С учетом симптомов, морфологических признаков, скорости прогрессирования и реакции на терапию различают следующие формы болезни:
- Хронический лимфолейкоз с доброкачественным течением. Состояние больного долго остается удовлетворительным. Отмечается медленное увеличение количества лейкоцитов в крови. С момента постановки диагноза до стабильного увеличения лимфоузлов может пройти несколько лет или даже десятилетий. Больные сохраняют трудоспособность и привычный образ жизни.
- Классическая (прогрессирующая) форма хронического лимфолейкоза. Лейкоцитоз нарастает в течение месяцев, а не лет. Отмечается параллельное увеличение лимфоузлов.
- Опухолевая форма хронического лимфолейкоза. Отличительной особенностью этой формы является нерезко выраженный лейкоцитоз при выраженном увеличении лимфоузлов.
- Костномозговая форма хронического лимфолейкоза. Выявляется прогрессирующая цитопения при отсутствии увеличения лимфатических узлов, печени и селезенки.
- Хронический лимфолейкоз с увеличением селезенки.
- Хронический лимфолейкоз с парапротеинемией. Отмечаются симптомы одной из вышеперечисленных форм заболевания в сочетании с моноклональной G- или M-гаммапатией.
- Прелимфоцитарная форма хронического лимфолейкоза. Отличительной особенностью этой формы является наличие лимфоцитов, содержащих нуклеолы, в мазках крови и костного мозга, образцах ткани селезенки и лимфоузлов.
- Волосатоклеточный лейкоз. Выявляются цитопения и спленомегалия при отсутствии увеличения лимфоузлов. При микроскопическом исследовании обнаруживаются лимфоциты с характерным «моложавым» ядром и «неровной» цитоплазмой с обрывами, фестончатыми краями и ростками в виде волосков либо ворсинок.
- Т-клеточная форма хронического лимфолейкоза. Наблюдается в 5% случаев. Сопровождается лейкемической инфильтрацией дермы. Обычно быстро прогрессирует.
Выделяют три стадии клинических стадии хронического лимфолейкоза: начальную, развернутых клинических проявлений и терминальную.
На начальной стадии патология протекает бессимптомно и может выявляться только по анализам крови. В течение нескольких месяцев или лет у больного хроническим лимфолейкозом выявляется лимфоцитоз 40-50%. Количество лейкоцитов приближено к верхней границе нормы. В обычном состоянии периферические и висцеральные лимфоузлы не увеличены. В период инфекционных заболеваний лимфатические узлы могут временно увеличиваться, а после выздоровления снова уменьшаться. Первым признаком прогрессирования хронического лимфолейкоза становится стабильное увеличение лимфоузлов, нередко - в сочетании с гепатомегалией и спленомегалией.
Вначале поражаются шейные и подмышечные лимфоузлы, затем - узлы в области средостения и брюшной полости, потом - в паховой области. При пальпации выявляются подвижные безболезненные плотноэластические образования, не спаянные с кожей и близлежащими тканями. Диаметр узлов при хроническом лимфолейкозе может колебаться от 0,5 до 5 и более сантиметров. Крупные периферические лимфоузлы могут выбухать с образованием видимого косметического дефекта. При значительном увеличении печени, селезенки и висцеральных лимфоузлов может наблюдаться сдавление внутренних органов, сопровождающееся различными функциональными нарушениями.
Пациенты с хроническим лимфолейкозом жалуются на слабость, беспричинную утомляемость и снижение трудоспособности. По анализам крови отмечается увеличение лимфоцитоза до 80-90%. Количество эритроцитов и тромбоцитов обычно остается в пределах нормы, у некоторых больных выявляется незначительная тромбоцитопения. На поздних стадиях хронического лимфолейкоза отмечаются снижение веса, ночные поты и повышение температуры до субфебрильных цифр. Характерны расстройства иммунитета. Больные часто страдают простудными заболеваниями, циститом и уретритом. Наблюдается склонность к нагноению ран и частое образование гнойников в подкожной жировой клетчатке.
Причиной летального исхода при хроническом лимфолейкозе часто становятся тяжелые инфекционные заболевания. Возможны воспаления легких, сопровождающиеся спаданием легочной ткани и грубыми нарушениями вентиляции. У некоторых больных развивается экссудативный плеврит, который может осложняться разрывом или сдавлением грудного лимфатического протока. Еще одним частым проявлением развернутого хронического лимфолейкоза является опоясывающий лишай, который в тяжелых случаях становится генерализованным, захватывая всю поверхность кожи, а иногда и слизистые оболочки. Аналогичные поражения могут наблюдаться при герпесе и ветряной оспе.
Осложнения
В числе возможных осложнений хронического лимфолейкоза - инфильтрация преддверно-улиткового нерва, сопровождающаяся расстройствами слуха и шумом в ушах. В терминальной стадии хронического лимфолейкоза может наблюдаться инфильтрация мозговых оболочек, мозгового вещества и нервных корешков. По анализам крови выявляются тромбоцитопения, гемолитическая анемия и гранулоцитопения.
Возможна трансформация хронического лимфолейкоза в синдром Рихтера - диффузную лимфому, проявляющуюся быстрым ростом лимфоузлов и формированием очагов за пределами лимфатической системы. До развития лимфомы доживает около 5% пациентов. В остальных случаях смерть наступает от инфекционных осложнений, кровотечений, анемии и кахексии. У некоторых больных хроническим лимфолейкозом развивается тяжелая почечная недостаточность, обусловленная инфильтрацией почечной паренхимы.
Диагностика
В половине случаев патологию обнаруживают случайно, при обследовании по поводу других заболеваний или при проведении планового осмотра. При постановке диагноза учитывают жалобы, анамнез, данные объективного осмотра, результаты анализов крови и иммунофенотипирования. Диагностическим критерием хронического лимфолейкоза является увеличение количества лейкоцитов в анализе крови до 5×109/л в сочетании с характерными изменениями иммунофенотипа лимфоцитов. При микроскопическом исследовании мазка крови выявляются малые В-лимфоциты и тени Гумпрехта, возможно - в сочетании с атипичными или крупными лимфоцитами. При иммунофенотипировании подтверждается наличие клеток с абберантным иммунофенотипом и клональность.
Определение стадии хронического лимфолейкоза осуществляют на основании клинических проявлений заболевания и результатов объективного осмотра периферических лимфоузлов. Для составления плана лечения и оценки прогноза при хроническом лимфолейкозе проводят цитогенетические исследования. При подозрении на синдром Рихтера назначают биопсию. Для определения причин цитопении выполняют стернальную пункцию костного мозга с последующим микроскопическим исследованием пунктата.
Лечение хронического лимфолейкоза
На начальных стадиях хронического лимфолейкоза применяют выжидательную тактику. Пациентам назначают обследование каждые 3-6 месяцев. При отсутствии признаков прогрессирования ограничиваются наблюдением. Показанием к проведению активного лечения является увеличение количества лейкоцитов вдвое и более в течение полугода. Основным методом лечения хронического лимфолейкоза является химиотерапия. Наиболее эффективной комбинацией лекарственных препаратов обычно становится сочетание ритуксимаба, циклофосфамида и флударабина.
При упорном течении хронического лимфолейкоза назначают большие дозы кортикостероидов, осуществляют пересадку костного мозга. У больных пожилого возраста с тяжелой соматической патологией использование интенсивной химиотерапии и пересадка костного мозга могут быть затруднены. В подобных случаях проводят монохимиотерапию хлорамбуцилом или применяют данный препарат в сочетании с ритуксимабом.
Хронический лимфолейкоз рассматривается как практически неизлечимое длительно текущее заболевание с относительно удовлетворительным прогнозом. В 15% случаев наблюдается агрессивное течение с быстрым нарастанием лейкоцитоза и прогрессированием клинической симптоматики. Летальный исход при этой форме хронического лимфолейкоза наступает в течение 2-3 лет. В остальных случаях отмечается медленное прогрессирование, средняя продолжительность жизни с момента постановки диагноза колеблется от 5 до 10 лет. При доброкачественном течении срок жизни может составлять несколько десятилетий. После прохождения курса лечения улучшение наблюдается у 40-70% больных хроническим лимфолейкозом, однако полные ремиссии выявляются редко.
Хронический лейкоз
Хронический лейкоз - это первичное опухолевое заболевание системы кроветворения, субстратом которого выступают зрелые и созревающие клетки миелоидного или лимфоидного ряда. Различные формы хронического лейкоза протекают с преобладанием интоксикационного (слабость, артралгии, оссалгии, анорексия, похудание), тромбогеморрагического (кровоточивость, тромбозы различной локализации), лимфопролиферативного синдромов (увеличение лимфоузов, спленомегалия и др.). Решающее значение в диагностике хронического лейкоза принадлежит исследованию ОАК, биоптатов костного мозга и лимфоузлов. Лечение хронических лейкозов проводится методами химиотерапии, лучевой терапии, иммунотерапии, возможна трансплантация костного мозга.



Хронический лейкоз - хронические лимфопролиферативные и миелопролиферативные заболевания, характеризующиеся избыточным увеличением количества кроветворных клеток, сохраняющих способность к дифференцировке. В отличие от острых лейкозов, при которых происходит пролиферация низкодифференцированных гемопоэтических клеток, при хронических лейкозах опухолевый субстрат представлен созревающими или зрелыми клетками. Для всех типов хронических лейкозов характерна длительная стадия доброкачественной моноклоновой опухоли.
Хронические лейкозы поражают преимущественно взрослых в возрасте 40-50 лет; мужчины болеют чаще. На долю хронического лимфоидного лейкоза приходится около 30% случаев, хронического миелоидного лейкоза - 20% всех форм лейкемии. Хронический лимфолейкоз в гематологии диагностируется в 2 раза чаще, чем хронический миелолейкоз. Лейкозы у детей протекают в хроническом варианте крайне редко - в 1-2% случаев.

Истинные причины, приводящие к развитию хронического лейкоза, неизвестны. В настоящее время наибольшее признание получила вирусно-генетическая теория гемобластозов. Согласно данной гипотезе, некоторые виды вирусов (в числе которых - вирус Эбштейна-Барр, ретровирусы и др.) способны проникать в незрелые кроветворные клетки и вызывать их беспрепятственное деление.
Не подвергается сомнению и роль наследственности в происхождении лейкозов, поскольку доподлинно известно, что заболевание нередко носит семейный характер. Кроме этого, хронический миелолейкоз в 95% случаев ассоциирован с аномалией 22-й хромосомы (филадельфийской или Рh-хромосомы), фрагмент длинного плеча которой транслоцирован на 9-ю хромосому.
Факторы риска
Наиболее значимыми предрасполагающими факторами к различным видам и формам хронических лейкозов выступают воздействия на организм:
- высоких доз радиации;
- рентгеновского облучения;
- производственных химических вредностей (лаков, красок и др.);
- лекарственных препаратов (солей золота, антибиотиков, цитостатиков);
- длительный стаж курения.
Риск развития хронического лимфоцитарного лейкоза повышается при длительном контакте с гербицидами и пестицидами, а хронического миелоидного лейкоза - при радиационном облучении.
В патогенезе хронического лимфолейкоза значимая роль принадлежит иммунологическим механизмам - об этом свидетельствует его частое сочетание с аутоиммунной гемолитической анемией и тромбоцитопенией, коллагенозами. Вместе с тем, у большинства больных хроническими лейкозами причинно значимых факторов выявить не удается.
В зависимости от происхождения и клеточного субстрата опухоли хронические лейкозы делятся на:
- Лимфоцитарные: хронический лимфолейкоз, болезнь Сезари (лимфоматоз кожи), волосатоклеточный лейкоз, парапротеинемические гемобластозы (миеломная болезнь, макроглобулинемия Вальденстрема, болезни легких цепей, болезни тяжелых цепей).
- Миелоцитарные (гранулоцитарные): хронический миелолейкоз, эритремия, истинная полицитемия, хронический эритромиелоз и др.
- Моноцитарные: хронический моноцитарный лейкоз и гистиоцитозы.
В своем развитии опухолевый процесс при хроническом лейкозе проходит две стадии: моноклоновую (доброкачественную) и поликлоновую (злокачественную). Течение хронического лейкоза условно подразделяется на 3 стадии: начальную, развернутую и терминальную.

Симптомы хронического лейкоза
Хронический миелоидный лейкоз
В начальном периоде хронического миелолейкоза клинические проявления отсутствуют или неспецифичны, гематологические изменения выявляются случайно при исследовании крови. В доклиническом периоде возможно нарастание слабости, адинамии, потливости, субфебрилитета, болей в левом подреберье.
Переход хронического миелоидного лейкоза в развернутую стадию знаменуется прогрессирующей гиперплазией селезенки и печени, анорексией, похуданием, выраженными болями в костях и артралгиями. Характерно образование лейкемических инфильтратов на коже, слизистых полости рта (лейкемический периодонтит), ЖКТ. Геморрагический синдром проявляется гематурией, меноррагией, метроррагией, кровотечениями после экстракции зубов, кровавыми поносами. В случае присоединения вторичной инфекции (пневмонии, туберкулеза, сепсиса и др.) температурная кривая приобретает гектический характер.
Терминальная стадия хронического миелоидного лейкоза протекает с резким обострением всех симптомов и выраженной интоксикацией. В этот период может развиваться плохо поддающееся терапии и угрожающее жизни состояние - бластный криз, когда из-за резкого увеличения количества бластных клеток течение заболевания становится похожим на острый лейкоз. Для бластного криза характерна агрессивная симптоматика: лейкемиды кожи, тяжелые кровотечения, вторичные инфекции, высокая температура, возможен разрыв селезенки.
Хронический лимфолейкоз
Долгое время единственным признаком хронического лимфолейкоза может быть лимфоцитоз до 40-50%, незначительное увеличение одной-двух групп лимфоузлов. В развернутый период лимфаденит принимает генерализованную форму: увеличиваются не только периферические, но и медиастинальные, мезентериальные, забрюшинные узлы. Возникает сплено- и гепатомегалия; возможно сдавление холедоха увеличенными лимфатическими узлами с развитием желтухи, а также верхней полой вены с развитием отеков шеи, лица, рук (синдром ВПВ). Беспокоят упорные оссалгии, кожный зуд, рецидивирующие инфекции.
Тяжесть общего состояния больных хроническим лимфоидным лейкозом обусловлена прогрессированием интоксикации (слабость, потливость, лихорадка, анорексия) и анемического синдрома (головокружение, одышка, сердцебиение, обморочные состояния).
Терминальная стадия хронического лимфоидного лейкоза характеризуется присоединением геморрагического и иммунодефицитного синдромов. В этот период развивается тяжелая интоксикация, возникают кровоизлияния под кожу и слизистые, носовые, десневые, маточные кровотечения.
Иммунодефицит, обусловленный неспособностью функционально незрелых лейкоцитов выполнять свои защитные функции, проявляется синдромом инфекционных осложнений. У больных хроническим лимфолейкозом часты легочные инфекции (бронхиты, бактериальные пневмонии, туберкулезные плевриты), грибковые поражения кожи и слизистых, абсцессы и флегмоны мягких тканей, пиелонефриты, герпетическая инфекция, сепсис.
Нарастают дистрофические изменения внутренних органов, кахексия, почечная недостаточность. Летальный исход при хроническом лимфоидном лейкозе наступает от тяжелых инфекционно-септических осложнений, кровотечений, анемии, истощения. Возможна трансформация хронического лимфолейкоза в острый лейкоз или лимфосаркому (неходжкинскую лимфому).
Предполагаемый диагноз устанавливается на основании анализа гемограммы, с результатами которой пациент должен быть немедленно направлен к врачу-гематологу. Для подтверждения диагноза проводится:
- Общий анализ крови. Типичные для хронического миелоидного лейкоза изменения включают: анемию, присутствие единичных миелобластов и гранулоцитов на разной стадии дифференцировки; в период бластного криза количество бластных клеток увеличивается более чем на 20%. При хроническом лимфолейкозе определяющими гематологическими признаками выступают выраженный лейкоцитоз и лимфоцитоз, наличие лимфобластов и клеток Боткина-Гумпрехта.
- Пункции и биопсии. С целью определения морфологии опухолевого субстрата показано выполнение стернальной пункции, трепанобиопсии, биопсии лимфоузлов. В пунктате костного мозга при хроническом миелолейкозе увеличено количество миелокариоцитов за счет незрелых клеток гранулоцитарного ряда; в трепанобиоптате определяется замещение жировой ткани миелоидной. При хроническом лимфоидном лейкозе миелограмма характеризуется резким усилением лимфоцитарной метаплазии.
- Инструментальные исследования. Для оценки выраженности лимфопролиферативного синдрома применяются УЗИ лимфатических узлов, селезенки, рентгенография грудной клетки, лимфосцинтиграфия, МСКТ брюшной полости и ряд других.
Лечение хронического лейкоза
На ранней доклинической стадии лечение неэффективно, поэтому больные подлежат динамическому наблюдению. Общережимные мероприятия предполагают исключение физических перегрузок, стрессов, инсоляции, электропроцедур и теплолечения; полноценное витаминизированное питание, длительные прогулки на свежем воздухе.
В развернутом периоде миелолейкоза назначается химиотерапевтическое лечение (бусульфан, митобронитол, гидроксимочевина и др.), при выраженной спленомегалии проводится облучение селезенки. Подобная тактика, хоть и не приводит к полному излечению, но существенно тормозит прогрессирование болезни и позволяет отсрочить наступление бластного криза. Кроме медикаментозной терапии, при хроническом миелоцитарном лейкозе используются процедуры лейкафереза. В ряде случаев излечение достигается с помощью трансплантации костного мозга.
При переходе хронического миелолейкоза в терминальную стадию назначается высокодозная полихимиотерапия. В среднем после установления диагноза больные хроническим миелолейкозом живут 3-5 лет, в отдельных случаях - 10-15 лет. Также проводится цитостатическая терапия (хлорбутин, циклофосфамид), иногда в сочетании со стероидной терапией, облучением лимфоузлов, селезенки, кожи. При значительном увеличении селезенки выполняется спленэктомия. Применяется трансплантация стволовых клеток, однако ее эффективность еще требует подтверждения.

Продолжительность жизни больных хроническим лимфоидным лейкозом может составлять от 2-3 лет (при тяжелых, неуклонно прогрессирующих формах) до 20-25 лет (при относительно благоприятном течении).
Читайте также:
